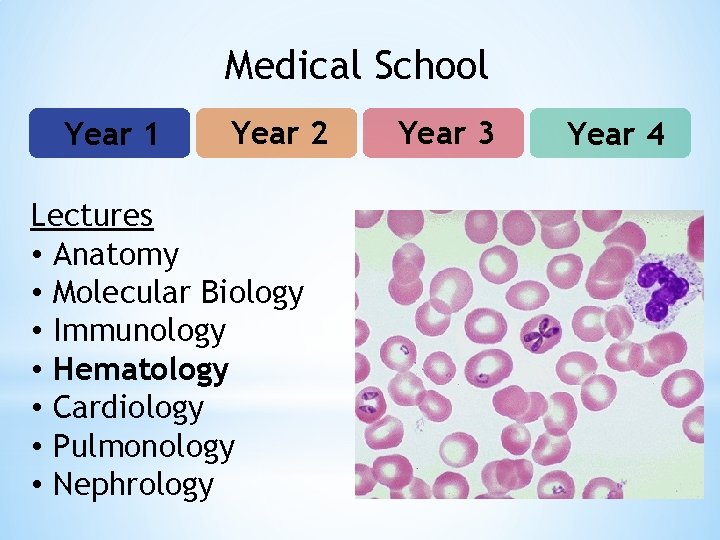
Medical School Year 1 Year 2 Lectures • Anatomy • Molecular Biology • Immunology

Choosing Medicine as a Career Danielle Gonzales MS

- Slides: 46
Choosing Medicine as a Career Danielle Gonzales, MS 3 University of Colorado School of Medicine
My Path • Hometown: Born and raised in Denver, CO.
My Path • Hometown: Born and raised in Denver, CO. • College: Stanford University, BA in Human Biology 2010 • Initially was an Economics major not for me • Did not know I wanted to go into medicine until Spring of my Junior year • Participated in various extracurricular activities related to medicine to decide if medicine was for me (I will get more into this later…) • Took 2 years off after college to finish requirements for medical school (more on this later as well…)
My Path • Hometown: Born and raised in Denver, CO. • College: Stanford University, BA in Human Biology 2010 • Medical School: University of Colorado School of Medicine
So Why Go Into Medicine? • To make a positive impact on people’s lives/health • “Play detective”/solve puzzles • Enjoy learning about medical science • Personal experience with medical system/medical professionals • Lifelong learning • Enjoy working within a team • Job demand
Different Medical Professions Profession HS CNA MA EMT Paramedic RN NP PA Pharm D MD Cert. Train College Grad. School Residency
* Education: * Short training program (~160 hours) * Pass certification test * Responsibilities: * Feed, bathe, dress patients * Take vital signs * Answer calls for help * Monitor changes in patients behavior and condition * Minute to minute patient care * Education: * Training program (9 -12 months for certificate or up to 2 years for associate’s degree) * Pass CMA certification exam * Responsibilities: * Administrative: update medical records, handle insurance forms and correspondence, scheduling, etc. * Clinical: collect lab specimens, perform basic lab tests, room patients and get preliminary information, etc.
* Education: * Training program 2 -6 months * Various levels of training ranging from 100 -350 hours of training * Pass National Registry of Emergency Medical Technicians (NREMT) certification exam * Responsibilities * Provide urgent medical care to patients in the field * Work with police and firefighters at the scene and transport patients to medical facilities * Provide CPR, oxygen, vital signs, bandaging/splinting, basic airway management * Education: * 2 year degree program in paramedic training * Many programs have a pre- requisite of college-level biology, math and English * Pass state licensing exam * Responsibilities: * More responsibilities, more job opportunities and higher salary than EMT (also requires more training) * Provide medications, endotracheal intubation (breathing tube), defibrillation, EKG monitoring, advanced airway management
* Education: * Bachelor of Science in Nursing: 4 year program * Graduate school: 2 year program * Pass National Council Licensure Exam (NCLEX)-RN * Responsibilities: * Take patient’s medical history and symptoms * Assisting physicians during surgery or treatment * Explain home care procedures * Provide emotional support to families * Help with patient follow-up * Dispense medications * Education: * Obtain nursing degree * Complete a master’s degree program for NP: 2 -4 years * Pass licensing exam * Responsibilities: * Mid-level provider * Can care for and develop patient care plans * Prescribe medications * All under the supervision of a physician * Typically in primary care, urgent care setting but there are other options
*Education: * 4 year college degree * 2 -4 year PA program * Pass licensing exam *Responsibilities: * Mid-level provider * Have more flexibility in the specialties that they can go into
*Education: * 4 year college degree * 4 year Pharmacy program * Pass licensing exam *Responsibilities: * Community pharmacist: control, dispense and advise patients about their medications * Hospital pharmacist: participate in hospital rounds, monitor medications for patients and control which medications are dispensed and dosages
*Education: * 4 year college degree * 4 year MD program * Pass multiple licensing exams * Complete residency in your chosen specialty (3 -7 years) * Can complete fellowship training to further specialize if desired *Responsibilities: * See patients and take comprehensive history and physical exam * Develop differential diagnoses for the various medical problems * Order labs and imaging and interpret results * Develop patient care plans * Correspond with other medical providers to coordinate care * Oversee PA and NP patient care
Other Medical Professions *Dentist *DO (osteopathic medicine) *Physical Therapist *Lab technician, etc.
Different Medical Professions Educational Debt Annual Income CNA $1, 500 $25, 000 MA $4, 000 $30, 000 EMT $5, 000 $30, 000 $8, 000 $30, 000 $65, 000 $50, 000 $90, 000 $100, 000 $90, 000 $200, 000 $190, 000 Paramedic RN NP PA MD
Road to Becoming A Doctor High School College Medical School Residency Fellowship? Attending
* Do the best you can do! * Study hard * Participate in extracurricular activities: * Sports, art, theater, music, whatever you enjoy doing * Volunteer * Have fun with medicine and get as much exposure as you can, enjoy it! * Shadow doctors/hospital * You can major in whatever you like: * Biology, Human Biology, English, Economics, etc. * Participate in extracurricular activities: * Same activities as high school * Research * Volunteer * Have fun with medicine and get as much exposure as you can, enjoy it! * Shadow doctors/hospital * Application process includes: personal statement, letters of recommendation, grades, MCAT score, interviews, etc.
How Much Does Medical School Cost? *It is expensive but worth it! * Investment in yourself * High job security with above average salary you will be able to pay off your debt *Scholarships are available * Armed Forces * MSTP, Primary Care, Rural, etc. * Academic and Diversity based scholarships
Medical School Year 1 Year 2 Year 3 Year 4
Medical School Year 1 Year 2 Lectures • Anatomy • Molecular Biology • Immunology • Hematology • Cardiology • Pulmonology • Nephrology Year 3 Year 4
Medical School Year 1 Year 2 Lectures • Anatomy • Molecular Biology • Immunology • Hematology • Cardiology • Pulmonology • Nephrology Year 3 Year 4
Medical School Year 1 Year 2 Lectures • Anatomy • Molecular Biology • Immunology • Hematology • Cardiology • Pulmonology • Nephrology Year 3 Year 4
Medical School Year 1 Year 2 Lectures • Anatomy • Molecular Biology • Immunology • Hematology • Cardiology • Pulmonology • Nephrology Year 3 Year 4
Medical School Year 1 Year 2 Lectures • Anatomy • Molecular Biology • Immunology • Hematology • Cardiology • Pulmonology • Nephrology Year 3 Year 4
Medical School Year 1 Year 2 Lectures • Anatomy • Molecular Biology • Immunology • Hematology • Cardiology • Pulmonology • Nephrology * Year 3 Year 4
Medical School Year 1 Year 2 Lectures • Anatomy • Molecular Biology • Immunology • Hematology • Cardiology • Pulmonology • Nephrology Year 3 Year 4
Medical School Year 1 Year 2 Lectures • Anatomy • Molecular Biology • Immunology • Hematology • Cardiology • Pulmonology • Nephrology Year 3 Year 4
Medical School Year 1 Year 2 Lectures • Neurology • Gastroenterology • Infectious Disease • Life Cycles • Psychiatry Year 3 Year 4
Medical School Year 1 Year 2 Lectures • Neurology • Gastroenterology • Infectious Disease • Life Cycles • Psychiatry Year 3 Year 4
Medical School Year 1 Year 2 Lectures • Neurology • Gastroenterology • Infectious Disease • Life Cycles • Psychiatry Year 3 Year 4
Medical School Year 1 Year 2 Lectures • Neurology • Gastroenterology • Infectious Disease • Life Cycles • Psychiatry Year 3 Year 4
Medical School Year 1 Year 2 Lectures • Neurology • Gastroenterology • Infectious Disease • Life Cycles • Psychiatry Year 3 Year 4
Medical School Year 1 Year 2 Lectures • Neurology • Gastroenterology • Infectious Disease • Life Cycles • Psychiatry Year 3 Year 4
Medical School Year 1 Year 2 Lectures • Neurology • Gastroenterology • Infectious Disease • Life Cycles • Psychiatry Year 3 Year 4
Medical School Year 1 Year 2 Lectures • Neurology • Gastroenterology • Infectious Disease • Life Cycles • Psychiatry Year 3 Year 4
Medical School Year 1 Year 2 Clerkships • Internal Medicine • Surgery • Family Medicine • Emergency Medicine • Pediatrics • Women’s Health • Psychiatry • Neurology Year 3 Year 4
Medical School Year 1 Year 2 Sub-Internships • Subspecialties • Career Exploration • Apply for Residency • R&R Year 3 Year 4
Clinical Workshops
Work With Homeless
Work Abroad
Tracks • CU-UNITE (Colorado Urban Underserved Interprofessional Health Training and Education) • Global Health • LEADS (Leadership, Education and Advocacy Development Scholarship) • Research • Rural • Women’s Care
Ambulance Ride-Along
Rocky Mountain Rescue
Flight For Life
Ski Patrol
Skiing